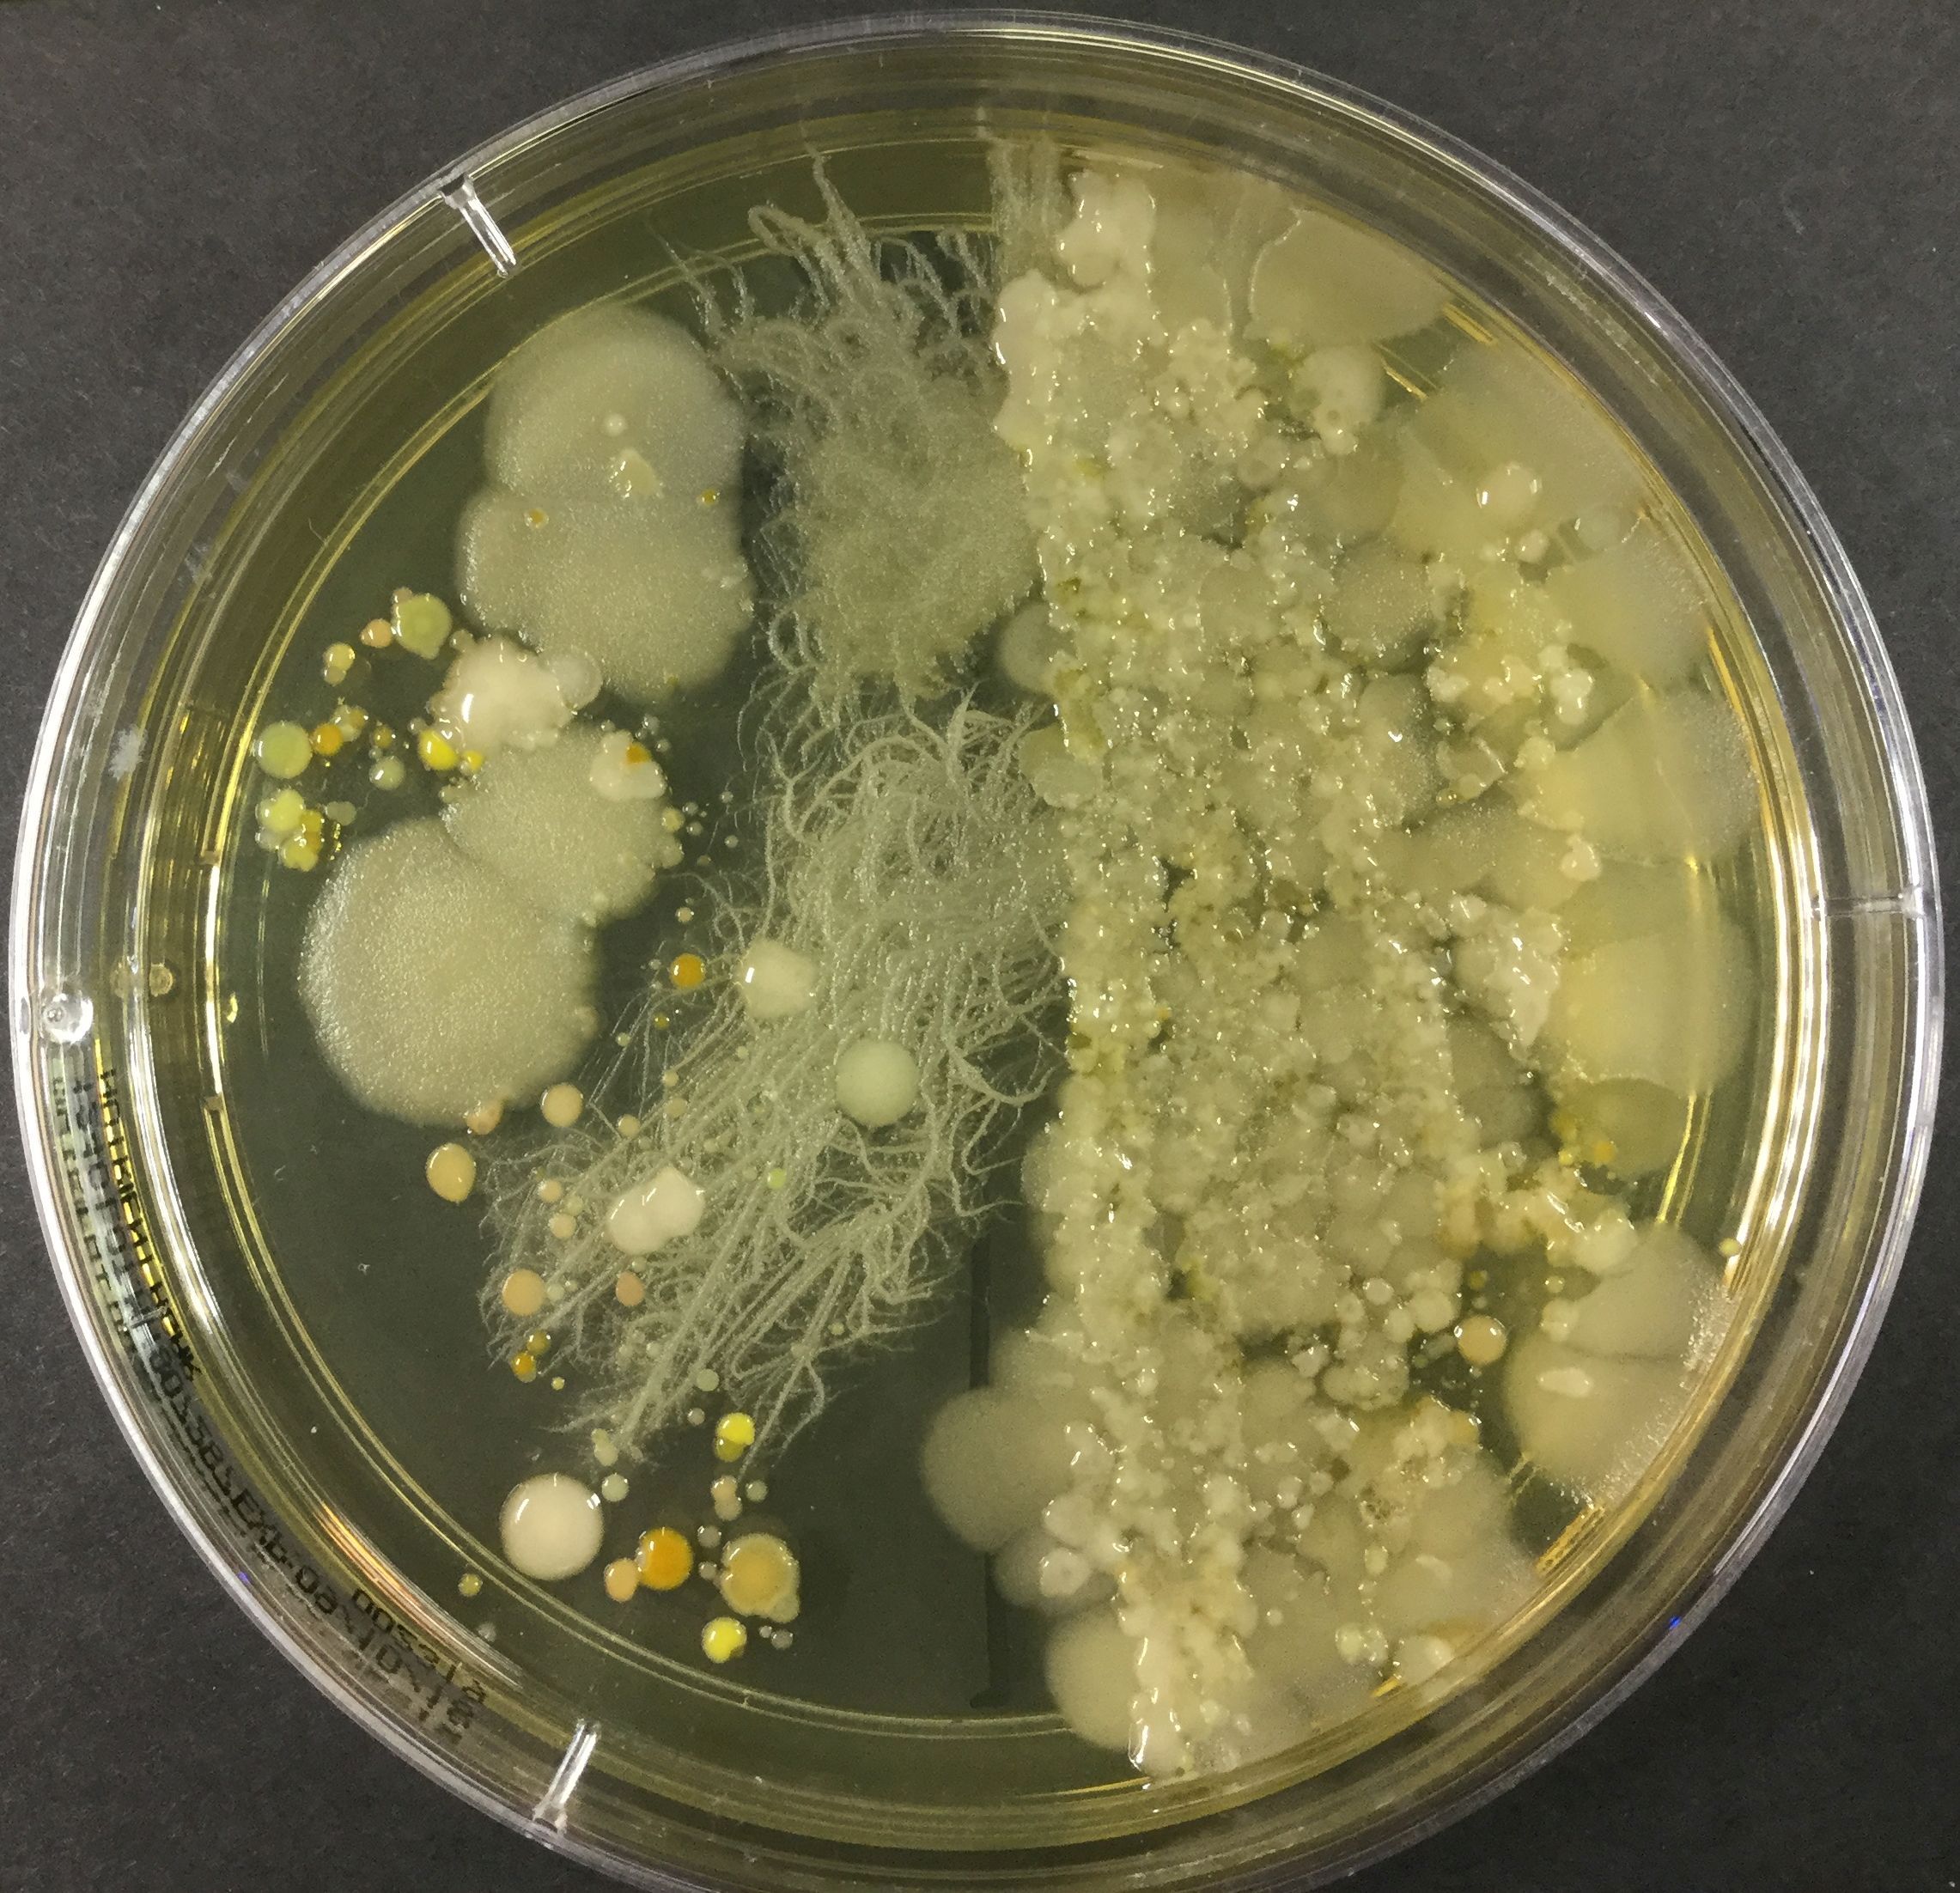
EnvironmentalContaminants.jpg

Our researchers are merging science and economics to fight a ‘silent killer’ that’s threatening millions of lives
Researchers at the University of South Australia are fighting against a killer that’s threatening lives, agriculture, and economies.
The World Health Organization has named it one of the “top 10 global threats facing humanity”, while the world’s highest-impact medical journal, The Lancet, calls it “the salient challenge of our time”.
This silent killer’ could potentially cause 10 million deaths annually by 2050, and yet, you’ve likely never heard of this issue until now.
Thankfully, some of Australia’s top researchers from the University of South Australia (UniSA) are developing solutions to this global problem, known as antimicrobial resistance.
These researchers have teamed up with industry partners to form Australia’s Cooperative Research Centre for Solving Antimicrobial Resistance in Agribusiness, Food and Environments (CRC SAAFE).
“While COVID killed 6.5 million people in less than three years and caused unimaginable grief and economic hardship, antimicrobial resistance was responsible for an estimated 4.95 million deaths in 2019 alone.”
Associate Professor Rietie Venter, UniSA
Millions of dollars to save millions of lives
Backed by $149 million, CRC SAAFE will tackle resistance to essential antibiotics, antifungals, and antivirals that, if not addressed, could wipe up to $283 billion from the Australian economy over the next 27 years.
At the helm of this mission is Research Director of the CRC SAAFE, Professor Erica Donner, who is an environmental scientist at UniSA.
Professor Donner’s team is finding the balance between managing disease in humans, animals, and plants, without rendering antimicrobials ineffective.
Professor Donner says the over-reliance on antimicrobials must be addressed in the next decade to save millions of lives and industries.
“We’re not just talking about human health, but animal and plant health as well, because antimicrobials are used every day in many different ways,” Prof Donner says.
“Many people fail to recognise that our reliance on antibiotics, pesticides, and antiseptics is encouraging microbes to develop resistance,” Prof Donner says. “Our dependence on them is the issue and we need greater stewardship.”
“Think of hospitals, aged care, animal production, horticulture, viticulture, aquaculture – all sites where antimicrobials are integral to treating and preventing disease.”
Improving diagnostics to decrease AMR rates
UniSA’s CRC SAAFE is bringing together partners from government, research, and industry to develop potential solutions and technologies that will manage and mitigate AMR.
Professor Donner says improving diagnostics is key to reducing the chances of using an antibiotic or pesticide that may not be effective.
“Currently, the world doesn’t have the right tools to know, categorically, which antimicrobials will be successful on a human patient or a wheat crop. There is still a lot of guesswork, due to lack of services and delays in lab tests,” Professor Donner says. “If the selected drug or pesticide is the wrong one, its use just compounds resistance.”
“If we can improve our point-of-use diagnostic tools, it will allow us to pick the right antimicrobial at first choice.”
Exploring natural alternatives and bacterial viruses to fight infection
If new diagnostics and new drugs are part of the answer to combating antimicrobial resistance, why is development taking so long?
The answer is simple, according to UniSA microbiologist Associate Professor Rietie Venter.
“Antibiotics are not profitable for pharmaceutical companies, costing on average $1.5 billion and taking at least a decade to develop, with no guaranteed return on investment.” Assoc Prof Venter says.
“Even if you do manage to develop an effective antibiotic, it is only used for a short period when there is an infection, and as a last resort, so there is little incentive for drug companies.
New incentives and payment models are therefore needed, Assoc Prof Venter says, along the lines of the United Kingdom’s decision to sponsor antibiotic development regardless of the outcome.
Assoc Prof Venter says there are also a handful of not-for-profit organisations committed to funding antimicrobial resistance, including Swiss company GARDP and US-based consortium CARB-X.
“On the one hand, we must develop new antibiotics faster, but we also need to slow down the development of AMR by reducing our use of antimicrobials,” Assoc Prof Venter says.
“Consumers also need to be made aware of the side effects of using household products like soaps, disinfectants, food packaging materials, cosmetics, electrical appliances and room sprays containing antimicrobials such as benzalkonium or nano silver.
“We need to find natural alternatives and invest in things like developing ‘resistance breakers’, compounds that can reverse antimicrobial resistance and rescue antibiotics,” Assoc Prof Venter says.
“Another option is phage therapy, using bacterial viruses to kill bacteria, instead of antibiotics. Alternatively, we can develop vaccines against very common infections.
“While COVID killed 6.5 million people in less than three years and caused unimaginable grief and economic hardship, antimicrobial resistance was responsible for an estimated 4.95 million deaths in 2019 alone.”
Merging economics with science to avert global impact
The numbers tell the story when it comes to the economic damage that antimicrobial resistance is expected to have on the world by 2050: global GDP is expected to fall by up to 4 per cent while global livestock production will drop by 7.5 per cent.
How can an economic lens help us to understand these potential risks and hopefully head them off at the pass, or at least mitigate them?
UniSA Economist and Senior Research Fellow, Dr Bethany Cooper, says it comes down to the supply and demand model.
“The supply of new antimicrobials and the demand for using them is what ultimately drives antimicrobial resistance,” Dr Cooper says.
“Alternatively, if it’s too easy to use the existing antimicrobials, or people don’t use them carefully, then we run the risk that too many will be circulating in the environment, making the germs adapt more quickly.”
Dr Cooper cites two case studies that she led in 2021, showing how economics can be applied to make better decisions around the treatment of AMR and its risks. An economic lens focused on the dairy industry, and wastewater management, illustrates how the overuse of antimicrobials impacts business and industry in the short and long term.
Mastitis is a common disease in dairy cows, causing abnormal and decreased milk production. It is treated with antibiotics, which, if used too frequently, can become ineffective.

This image was created with the assistance of DALL·E 2
Antibiotic residues are also harmful, causing sensitivity and allergic reactions in humans. What’s more, Antimicrobial-resistant bacteria also thrive in wastewater treatment plants and are notoriously difficult to remove, even with chlorine and ultraviolet light.
Dr Cooper says upgrading wastewater treatment plants to help break down pharmaceuticals better and remove AMR bacteria comes at a cost, but that must be weighed up against the benefits.
“We need to explore alternative treatments like membrane bioreactors, ozone and activated coal in wastewater to control AMR,” Dr Cooper says.
“There are solutions at hand that will reduce antimicrobial resistance – both economic and scientific – but political will is needed, along with a heightened sense of urgency and more research to find the optimal solutions.
“We don’t have time to waste.”






